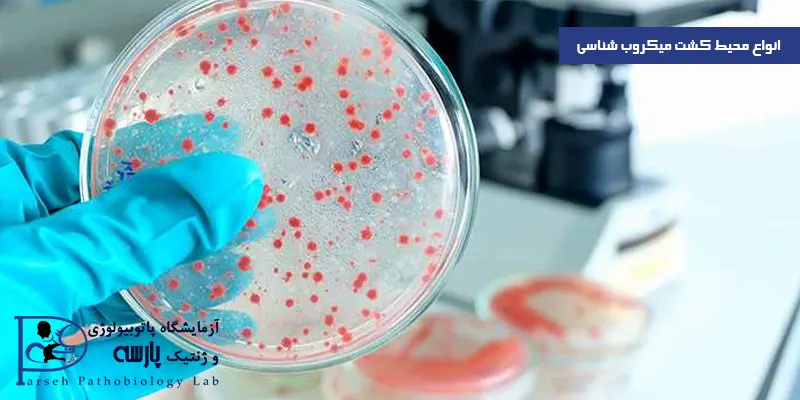
انواع-محیط-کشت-میکروب-شناسی
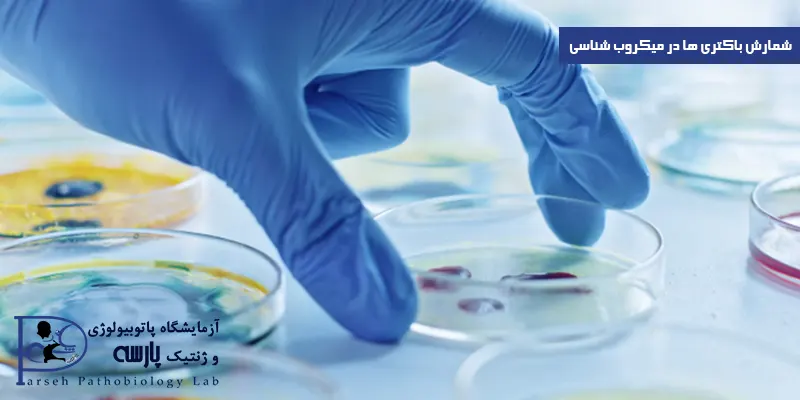
شمارش-باکتری-ها-در-میکروب-شناسی

میکروب شناسی علمی است که به مطالعه میکروارگانیسمها به ویژه باکتریها، ویروسها، قارچها و پارازیتها پرداخته و همچنین بر روی ساختار، عملکرد، رشد و تکامل این میکروارگانیسمها نیز تمرکز دارد و با استفاده از آن می توان بیماریها، زیستفناوری، محیط زیست و بهداشت را بررسی کرد.

میکروب شناسی با استفاده از روشهای مختلفی مانند کشت و کشف می تواند میکروارگانیسمها را شناسایی کرده و به پیشگیری، تشخیص و درمان بیماریها و همچنین توسعه واکسنها و آنتیبیوتیکها کمک بسیار زیادی خواهد کرد.
میکروب شناسی به چه علت انجام می شود؟
تنوع زیستی موجود در میکروارگانیسم ها ( موجوداتی که مستقیماً با چشم غیر مسلح دیده نمی شوند ) به گونه ای است که در هیچ قسمت دیگر از زیست شناسی دیده نمیشود. بررسی موشکافانه میکروارگانیسم ها از لحاظ شکل، عملکرد و ویژگی های بیوشیمیایی یا مکانیسم ژنتیکی، ما را به مرزهای دانش زیست شناسی رسانده است. بنابراین نیاز به نوآوری که آزمونی است برای تعیین کیفیت یک فرضیه علمی، بطور کامل در میکروب شناسی پاسخ داده میشود. یک فرضیه مفید باید اساسی برای تعمیم دهی قوانین ایجاد کند و تنوع میکروبها، میدانی برای این مبارزه دائمی به شمار میرود.
برای تحلیل میکروارگانیسم ها به چه ابزارهایی نیاز است؟
پیشبینی پدیده ها که نتیجه عملی دانش است، حاصل ترکیبی از تکنیک و فرضیه است. بیوشیمی، بیولوژی مولکولی و ژنتیک ابزارهای مورد نیاز برای تحلیل میکروارگانیسم ها را فراهم میآورند. میکروب شناسی نیز به نوبه خود، افق این علوم را گسترش میدهد. یک بیولوژیست چنین مبادله ای را تشریک مساعی مینامد، یعنی هر جزء به تمام قسمتهای دیگر سود میرساند و گلسنگ ها مثالی از تشریک مساعی میکروبی هستند.
گلسنگ ترکیبی از یک قارچ و یک ارگانیسم نورگرا ( فتوتروپ ) است که میتواند یک جلبک (که یوکاریوت است) و یا یک سیانوباکتری (که پروکاریوت است) باشد.
عضو نورگرا، تولید کننده اصلی است در حالی که قارچ تکیه گاه و سرپناهی برای این عضو فراهم میکند. در بیولوژی، به این حالت همزیستی اطلاق میشود که به معنای ارتباط مداوم ارگانیسم های مختلف میباشد. در صورتی که در این مبادله، یک طرف عمدتاً سود ببرد، این ارتباط به عنوان رابطه انگلی شناخته میشود که در آن، یک میزبان نیاز انگل را بر طرف میکند. برای جدا سازی و تعیین ویژگی های یک انگل مثلا یک باکتری بیماریزا یا ویروس، غالباً باید بتوان شرایطی مشابه سلول میزبان را در آزمایشگاه جهت رشد انگل فراهم نمود. این امر گاهی یک مشکل عمده برای محقق به شمار میرود.
ارتباطات بیولوژیک در میکروب شناسی
کلمات symbiosis, mutualism و parasitism به دانش اکولوژی (بوم شناسی) تعلق دارند و استفاده از اصول بیولوژی محیطی را در میکروب شناسی نشان میدهند. میکروارگانیسم ها حاصل روند تکامل هستند، یعنی محصولات بیولوژیک انتخاب های طبیعی از شاخه های گوناگون ارگانیسم های متنوع (از لحاظ ژنتیکی) هستند. البته قبل از تعمیم دادن این اصل به میکروارگانیسم ها که ناهمگون ترین گروه از موجودات زنده هستند، بهتر است پیچیدگی تاریخ حیات را در نظر گرفت.
در طبقه بندی بیولوژیک موجودات زنده، یک شاخه بزرگ را یوکاریوتها مینامند که در ارگانیسم ها، هسته توسط غشایی احاطه شده است. شاخه دیگر پروکاریوت ها هستند که در این ارگانیسم ها، DNA به صورت فیزیکی از سیتوپلاسم جدا نشده است. البته تفاوت های بیشتری بین یوکاریوتها و پروکاریوتها میتوان قائل شد، مثلاً یوکاریوتها نسبت به پروکاریوتها اندازه بزرگتری دارند و دارای اندامک های (ارگانل) تخصصی هستند که توسط غشاء مانند میتوکندریها محدود شدهاند.
چشماندازی به سلول های میکروبی
همانطور که در مطالب بعدی شرح داده خواهد شد، یوکاریوتهای میکروبی به عنوان آغازیان نامیده میشوند و شاخه های عمده این گروه شامل جبلکها، تک یاخته ها، قارچها و کپکها هستند.

خصوصیات منحصر به فرد ویروسها، آنها را در جایگاهی متفاوت با سایر موجودات زنده قرار میدهد. یوکاریوتها و پروکاریوتها، موجودات زنده هستند زیرا حاوی تمام آنزیم های لازم برای تکثیر خود هستند، ابزارهای بیولوژیک لازم برای تولید انرژی متابولیک را دارا میباشند. بنابراین یوکاریوتها و پروکاریوتها از ویروسها متمایز هستند، زیرا ویروسها برای این عملکردهای ضروری به سلولهای میزبان وابسته هستند.
تکنیک های آزمایشگاهی میکروب شناسی
تکنیکهای آزمایشگاهی در میکروب شناسی به دانشمندان این امکان را میدهند تا میکروارگانیسمها را شناسایی، جداسازی، رشد و شمارش کنند.این تکنیکها به طور گسترده در آزمایشگاههای میکروبیولوژی و میکروب شناسی انجام می شوند که در ادامه برخی از تکنیکهای مهم در زمینه میکروب شناسی را بررسی خواهیم کرد.
جداسازی میکروارگانیسمها
در این تکنیک میکروارگانیسمها از نمونههای مختلف محیطی یا بالینی جدا خواهند شد که این جداسازی شامل رقیق کردن نمونه، کشت روی محیطهای باکتریایی یا قارچی مخصوص، و همینطور استفاده از محیطهای خاص نگهداری و رشد و استفاده از روشهای مولکولی مانند PCR میشود.
رشد میکروارگانیسمها
برای رشد میکروارگانیسمها، انواع محیطهای کشت نظیر محیطهای جامد مانند محیطهای آگار، محیطهای مورد نیاز برای رشد قارچها و محیطهای غلظت شده مانند محیطهای مانیتول نمکی وجود دارند. همچنین، محیطهای مایع مانند محیطهای نمکی، محیطهای آبی، و محیطهای غنی شده مانند محیطهای تریپتون سویا نیز به منظور رشد میکروارگانیسم ها مورد استفاده قرار میگیرند.
شمارش میکروارگانیسمها
از روشهای مختلفی برای شمارش سلولها و میکروارگانیسمها استفاده می شود که شامل شمارش باکتریها با استفاده از سیستمهای شمارش خودکار، استفاده از لوئوکایتومتر، و استفاده از روشهای طبقهبندی مانند روش کولیفورم میشود.
انواع محیط کشت میکروب شناسی
انواع محیط های کشت در میکروب شناسی وجود دارند که شرایط مناسبی را برای رشد و تکثیر میکروارگانیسمها فراهم خواهند کرد. این محیط ها شامل محیط های جامد و مایع هستند که بر اساس نوع میکروب و هدف آزمایش مورد استفاده قرار میگیرند. در زیر، نمونههایی از انواع محیط های کشت میکروب شناسی را بررسی خواهیم کرد.
محیطهای کشت جامد
این محیط ها دارای دو نوع هستند که توضیحات زیر را در خصوص این دو نوع محیط جامد ارائه دادیم:
محیط آگار
یکی از محیطهای کشت جامد که به طور عمومی برای رشد و جداسازی باکتریها استفاده میشود محیط آگار است و این محیط شامل پپتون، نمک، و گلوکز است.
محیط سابورو
یکی از محیط کشت جامد دیگر که برای رشد و شناسایی قارچها استفاده میشود محیط سابورو نام دارد که این محیط شامل آگار، نمک، سوربیتول، و اوره است.
محیطهای کشت مایع
سه نوع محیط کشت مایع داریم که عبارتند از:
محیط نمکی
یک محیط کشت مایع که شامل نمک و آب است محیط نمکی نام دارد. این محیط به طور عمومی برای رشد و کشت باکتریهایی که در محیط های نمکی طبیعی مانند باکتری هالوفیل یافت میشوند، استفاده میشود.
محیط تریپتون سویا
یک محیط کشت مایع چند منظوره که شامل پپتون، سویا بینهای، نمک و گلوکز است و این محیط برای رشد و کشت باکتریها و قارچها استفاده میشود.
محیط سیمونز مالت
یک محیط کشت مایع که شامل آب، مالتوز، پپتون، و نمک است. و از این محیط در واقع برای رشد و کشت باکتریها و قارچها استفاده میشود.
محیطهای انتخابی
سه نوع محیط انتخابی داریم که عبارتند از:
محیط مکانلکی
یک محیط انتخابی که برای رشد و جداسازی باکتریهای کلوستریدیوم (Clostridium) استفاده میشود محیط مکانلکی نام دارد، این محیط شامل عناصری مانند گلوکز، اگار، آمینوگلیکوزید و سولفیت است.
محیط مانیتول نمکی
یک محیط انتخابی که برای تشخیص و جداسازی باکتریهایی که قادر به متابولیسم مانیتول هستند مورد مورد استفاده قرار میگیرد محیط مانیتول نمکی نام دارد و این محیط شامل منیتول، نمک، و نشاسته است.
محیطهای خاص
محیط های خاص شامل محیط مکسوسکی است که در واقع برای رشد و جداسازی باکتریهای لاکتوز منفعل استفاده میشود. این محیط شامل لاکتوز، آگار، نمک، و اندامهای تشکیلدهنده مخصوص است.
شمارش باکتری ها در میکروب شناسی
یکی از مهمترین فعالیتها در زمینه میکروب شناسی شمارش باکتری ها است. این فرایند این امکان را میدهد تعداد باکتریهای موجود در یک نمونه را اندازهگیری کرده و از آن برای تحلیل و بررسی مسائل مختلف استفاده کرد. در ادامه توضیحاتی در مورد روشهای شمارش باکتریها در میکروب شناسی خواهیم داد.
شمارش مستقیم
در این روش، تعداد باکتریها به صورت مستقیم شمارش می شود که شامل دو روش اصلی است.
شمارش دستی
در این روش، نمونه تقسیم شده و بر روی ظروف حاوی محیط کشت قرار خواهد گرفت در مرحله بعد باکتریها روی ظروف رشد کرده و تعداد کلونیها (کلونیهای کشت شده) شمارش میشود و در نهایت نتیجه به صورت واحد تشکیل کلونی (CFU) در هر واحد حجم یا وزن گزارش میشود.
شمارش با استفاده از کامرا قابل شمارش
در این روش، باکتریهای موجود در نمونه با استفاده از کامراهای گلوریفوسین شمارش میشوند. در واقع باکتریها با نوری که از داخل دستگاه به آنها تابیده می شود رنگ شده و تعداد آنها شمارش میشود.
شمارش غیرمستقیم
در این روشها، تعداد باکتریها از طریق اندازه گیری یک شاخص دیگر به دست میآید.
شمارش توریدیمتری
این روش بر اساس اندازه گیری جریان الکتریکی سنجیده می شوند بدین صورت که باکتریهای بیشتر، جریان الکتریکی بیشتری تولید میکنند و بر اساس این جریان، تعداد باکتریها محاسبه خواهند شد.
شمارش انتقالی
در این روش، نمونه تقسیم شده و باکتری ها روی ظروف حاوی محیط کشت، کاشته شده و سپس، باکتریها روی ظروف رشد خواهند کرد و پس از یک دوره زمانی مشخص نمونهها تقسیم میشوند و باکتریها روی ظروف دیگری دوباره کشت میشوند. این فرآیند تا زمانی که باکتریها به اندازهای مشخص رشد کنند ادامه پیدا خواهد کرد و در نهایت با توجه به تعداد ظروفی که باکتریها روی آنها رشد کردهاند، تعداد باکتریها محاسبه میشود.
شمارش نیترات ردوکتاز
در این روش، با استفاده از یک آزمایش شیمیایی، تعداد باکتریهایی که قادر به تجزیه نیترات به نیتریت هستند، شمارش شده و این فرایند بر اساس تغییرات رنگی ایجاد شده در آزمایش انجام میشود.
مهم است بدانید که…
میکروب شناسی پزشکان و دانشمندان را قادر خواهد ساخت تا باکتریها را شناسایی کرده و همچنین رفتار آنها را در محیط زیست نیز مورد بررسی قرار دهند. یکی دیگر از کابردهای میکروب شناسی بررسی اثرات آنها بر سلامت انسان و محیط زیست بوده می توان با استفاده از این علم، بیماریهای عفونی را شناسایی و درمان کرده، واکسنها را توسعه داده و بهداشت عمومی را نیز بهبود بخشید.
